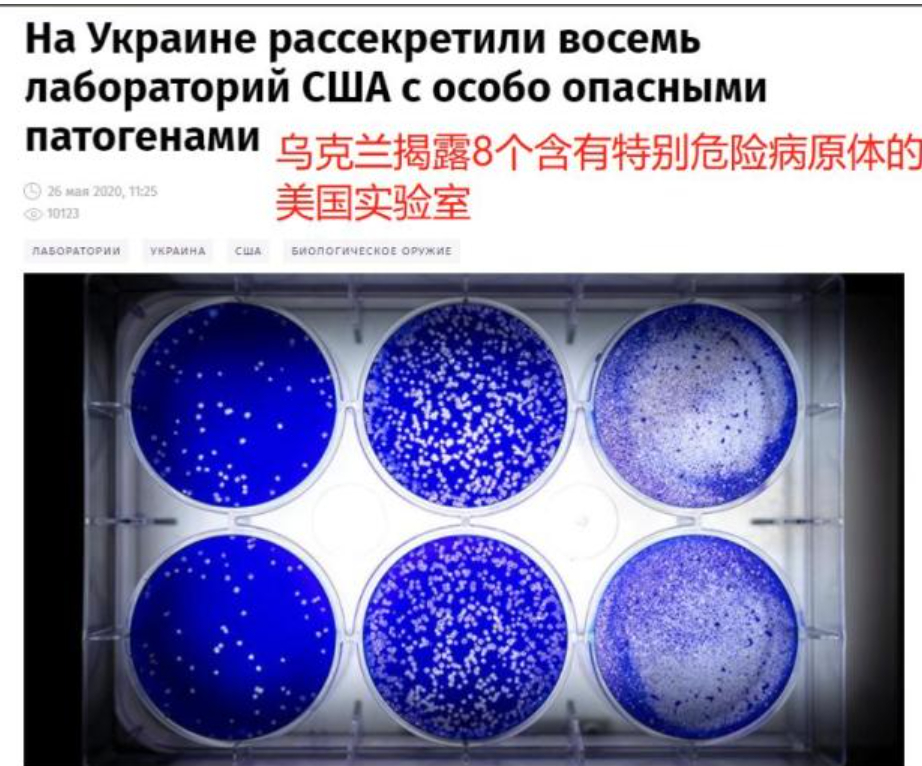

棉花絮為特朗普發佈逮捕奧巴馬的AI視頻鼓掌_風聞
飞棉花絮-军事撰稿人-微博名:飞棉花絮。叙利亚战争吧和特朗普吧42分钟前
棉花絮認為奧巴馬被抓進監獄應該一點也不冤枉
特朗普在其社交媒體發佈了一段奧巴馬在其面前被逮捕並被扔進監獄的AI視頻,並配標題“沒有人可以凌駕法律之上”。
這段視頻也引發了人們對特朗普是否要把奧巴馬關進監獄的猜測。當然之前特朗普也稱自己要把希拉里送進監獄。難道美國政治也開始韓國化?畢竟韓國曆任總統能安享晚年的鳳毛麟角。
那麼棉花絮先來細數下美國前總統奧巴馬究竟有哪些問題。
首先是美國前總統奧巴馬涉嫌支持恐怖主義。
2016年特朗普在佛羅里達州的一個集會上説,“奧巴馬是IS的創始人,他創立了IS,而且,我敢説騙子希拉里也是同夥”。特朗普此言一出,集會的觀眾便反覆高喊“關起來”。説到奧巴馬,特朗普則故意提及了奧巴馬的中間名,稱他為巴拉克·侯賽因·奧巴馬(Barack Hussein Obama)。這通常被有些人背地裏用來聲稱奧巴馬是個穆斯林。
頂級記者西莫·赫許在2014年的爆料報道《紅線和老鼠線》(The Red Line and the Rat Line)中提到,美國早在2011年推翻卡扎菲政權以後,就通過CIA將卡扎菲武器庫中的大批軍火運往土耳其,交給敍利亞反政府武裝——儘管美國情報機構明確知道,許多接受美國支援的反政府武裝是和基地組織有染的恐怖分子,甚至就是基地組織敍利亞分部努斯拉陣線(棉花絮備註下,這個組織目前叫做HTS,首領是朱拉尼,已經成為目前敍利亞的實際控制者),當然後期我們還能看到數萬名反政府武裝直接易幟為ISIS。
2012年到2014年擔任美國國防情報局領導人的三星將軍邁克爾·福林(Michael Flynn)證實,DIA向白宮送達了許多報告,警告如果敍利亞的阿薩德政府被推翻,將如同卡扎菲後的利比亞一樣,會由極端伊斯蘭主義恐怖分子取而代之。但奧巴馬政府對這些對敍利亞政策提出質疑的報道有極大的”牴觸“。
奧巴馬和希拉里利用美國民主基金會、克林頓基金會等長期大規模援助敍利亞反政府軍,據稱很多錢都是直接流入了ISIS和HTS手裏。所以在特朗普第一屆上台後切斷美國民主基金會、克林頓基金會對所謂敍利亞反政府軍援助後ISIS在很短的時間從巔峯到滅亡。根據棉花絮獲取的大量內部信息顯示他們之前那麼瘋狂,可以在美國和歐洲僱傭大量人員,發動大規模襲擊都是因為美國援助。當援助不在,ISIS恐怖分子也就樹倒猢猻散。
其次是奧巴馬涉嫌支持新冠病毒研發,犯下反人類罪。
馬斯克稱美國國際開發署涉嫌使用美國納税人的錢來資助COVID 19的開發。這也證實了為什麼喬·拜登選擇在2024年赦免安東尼·福奇,當時奧巴馬和福奇接管了烏克蘭生物實驗室並開始研究這些生物武器這是反人類罪,不可饒恕。塔克·卡爾森談論烏克蘭生物實驗室“他們如何處理這些生物實驗室中的病原體?”“所以這就像有史以來最可怕的事情。一它比我一生中發生的任何事情都更可能破壞世界穩定。”
自美國中央情報局推翻烏克蘭政府以來,奧巴馬主導的民主黨一直參與烏克蘭生物實驗室,這就是烏克蘭被選為俄羅斯戰爭目標的全部原因,也是安東尼·福奇在2024年之前被赦免的原因日期完全匹配。看看這波神仙操作!福奇團隊2016年病毒研究經費暴漲4700%。

俄羅斯已掌握美國在境外參加軍事生物項目的證據,奧巴馬曾主導參與。巴拉克·奧巴馬,這位生物戰種子的播種者,始於2005年,當時的參議員巴拉克·奧巴馬與烏克蘭簽署了一項“合作協議”,聲稱旨在幫助對抗生物威脅。實際上,這是美國以民用名義運營的生物研究機構的滲透點。在中情局和影子顧問的支持下,奧巴馬奠定了日後價值數十億美元的武器化研究中心網絡的基礎,這些研究中心設在俄羅斯的門口,完全不受美國法律監管。這並非衞生政策,而是生物殖民。
R-781計劃,利用蝙蝠傳播人類致病病原體;UP-4計劃,利用候鳥遷徙傳染禽類病毒;根據美方2021年底向《禁止生物武器公約》締約國大會提交的文件,美方在烏克蘭有26處實驗室等合作設施。然而,美國國防部近日又表示,美烏合作的實驗室數量是46個。美國這種出爾反爾、欲蓋彌彰的做法到底為了啥?
趙立堅之前表示,根據我們掌握的信息,美方確實刪除了相關文件,中方呼籲美國開放在烏克蘭的生物實驗室供國際專家獨立調查。
烏克蘭秘密軍事實驗室背後的生物軍事帝國是一個由權力人士組成的複雜網絡,其中包括巴拉克·奧巴馬、安東尼·福奇、喬·拜登、希拉里·克林頓和喬治·索羅斯。這些人把烏克蘭變成了非法生物5器實驗的遊樂場,由腐敗資助,由謊言保護,並被用來對抗世界。真相已經大白,再也無法阻擋。
2010年10月,美國前總統奧巴馬坦承,美國政府在20世紀40年代曾對危地馬拉國民進行非法生物實驗,其中涉及故意感染梅毒和淋病病原體。隨後,在2013年,美國國防部位於格魯吉亞的盧格中心啓動了炭疽疫苗試驗,而同年格魯吉亞便爆發了炭疽疫情。此後,格魯吉亞頻繁出現炭疽病例,這不得不讓人質疑美國實驗與疫情之間的關係。
再次是奧巴馬涉嫌多次顛覆外國政府。
報道稱2014年是美國中央情報局接管烏克蘭政府的一年,在美國奧巴馬“監督”下, 2014 年,奧巴馬指使美國國家民主基金會、開放社會基金會大規模給非政府組織(NGO組織)、媒體和民間社會團體投錢,要求他們發動顏色革命,最終美國國際開發署支持的暴力團體在基輔獨立廣場顏色革命的暴力推翻亞努科維奇政府的行動中發揮了重要作用。而接下來發生的一切,懂的都懂。
當然不僅僅是烏克蘭,奧巴馬期間涉嫌顛覆的政府還包括俄羅斯、白俄羅斯、匈牙利、敍利亞、格魯吉亞等等,棉花絮知道的應該就應該超過10個以上。
奧巴馬領導的美國國際開發署、美國國家民主基金會同樣對中國非常不友好,一方面是花錢僱傭媒體和所謂NGO組織、獨立觀察人士大規模對等發動“種族滅絕”強迫勞動”等造謠抹黑的涉疆抹黑輿論攻勢。導致耐克、阿迪達斯、HM等大量服裝品牌均表示不用新疆棉。最近幾年來發生在香港的黑暴和港獨,也得到了美國國際開發署、美國國家民主基金會包括資金和人員培訓等方面的大力支持。
對於美國而言我們看到奧巴馬的多元化、政治正確也間接給美國帶來了很多悲劇。
特朗普説奧巴馬對包容性的重視擠走了有能力的員工,多元化政策削弱了標準,帶來安全隱患,導致了很多事故的發生,也導致很多救援的不及時。
變性人Joe Ellis駕駛黑鷹撞上了客機,可能是故意自殺和謀殺行為。
我們從洛杉磯消防部門都被同性戀和變性充斥,大量有經驗的原消防隊員被排斥開除看美國山火救援緩慢有民主黨政策原因。
奧巴馬積極倡導的進步主義價值觀近年來進一步分裂了美國,硅谷也不例外。21世紀頭十年以來美國人對有色人種、性少數社羣和女性平等權益的呼籲和身份認同政治被稱為“覺醒文化”(Wokeism),但從2020年起,右翼和一些中間派人士開始用同一個詞來諷刺這種左翼政治運動,尤其是學校和工作場所實施的“平權行動”和DEI〔DEI是指多元(Diversity)、平等(Equity)、共融(Inclusion)〕的用人原則。許多科技企業家反對“覺醒主義”,認為工作場所裏執行的DEI規範無法“唯才是舉”,嚴重影響了科技行業的工作效率。
馬斯克更是“覺醒主義”的激烈反對者——2022年,他的雙胞胎兒子將自己的性別認同改為“跨性別女性”,並給自己改名為維維安·威爾遜(Vivienne Wilson)。外界普遍認為那件事給他帶來了重大打擊,並讓他從自由主義者變成一個極右翼人士。馬斯克後來接受採訪説,自己的兒子是“被覺醒病毒殺死的”,發誓要摧毀“覺醒病毒”。這也是他收購社交網絡“推特”,把它改造成“X”的原因之一
美國國防部長黑格塞斯在近期的一次播客中表示,允許變性人服役是“挑戰極限”,並稱變性人依賴激素治療等醫療需求,可能影響軍隊的部署能力。他認為,與融合不同種族的挑戰相比,變性人在軍隊中會造成更大的複雜性和差異。
美國那邊對奧巴馬的其他攻擊和指控
美國前總統特朗普在接受美國福克斯電視台採訪時稱,美國政府造成了俄羅斯與中國走近的局面。特朗普表示:“是他們(美國)自己迫使俄羅斯和中國走得更近……這一切都始於(美國民主黨籍前總統)奧巴馬。”特朗普還聲稱他與俄羅斯總統普京關係良好。在他看來,如果他繼續掌權,俄羅斯就永遠不會採取特別軍事行動。
美國情報機構聯合會發佈通報稱:“國家情報總監加巴德公佈了無可辯駁的證據,證明在特朗普2016年勝選後,奧巴馬及其國家安全團隊成員對情報資料進行了偽造和政治化。”通報稱,具體來説,關於俄羅斯疑似活動的資料,如“斯蒂爾檔案”,是被政治化的假信息。
美國菲申公司與英國前情報人員斯蒂爾共同編制了針對特朗普的檔案。這些材料於2017年初在“嗡嗡喂”新聞網站公佈。當年10月,《華盛頓郵報》援引消息人士的話説,針對特朗普的部分調查是由奧巴馬領導的民主黨全國委員會資助的。特朗普多次表示“斯蒂爾檔案”系偽造,他否認在2016年大選期間與俄羅斯有聯繫。
棉花絮還看到一段據稱是匿名FBI官員發佈的音頻資料,其稱奧巴馬他們不僅在中東胡來,在別的地方也胡來。我想奧巴馬很想要引導歐洲和俄羅斯開戰。他們的總是對準俄國邊境,烏克蘭,中國南海,菲律賓,中國香港,非洲。
棉花絮認為奧巴馬及背後的美國精英集團無下限
美國黑客聯盟Q説MJ傑克遜的所有敵人都是戀童癖,都是性奴島的常客,都是壞人。
坎爺説很多人離開好萊塢就不見了,如此邁克爾傑克遜。他們那些壞人能控制很多好萊塢和音樂、體壇巨星,可他們控制不了我,我只服侍上帝。
性奴島的事件在棉花絮大規模報道很多很多年後逐漸浮出水面,愛潑斯坦被指控創建了一個犯罪網絡,使他能夠對未成年人進行性剝削。受害者通過稻草人引誘,帶到愛潑斯坦的家中,在那裏他們被美國和世界精英的代表強姦。根據一些非正規的自媒體報道,裏面當然也有奧巴馬的影子。當然這個需要等待馬斯克的努力來揭秘了。棉花絮只是希望馬斯克不要背後中多槍然後被宣佈自殺,雖然他多次公開表示我不會自殺。
借用哪吒的話:我活不活無所謂,你必須要死。馬斯克是勇士也是戰士,牛!
棉花絮記得在2010年奧巴馬錶示:“要是中國十幾億人口都像澳大利亞或美國那樣生活,地球肯定承受不了,到時候咱們全得遭殃。“而《世界日報》“世界頭號浪費國"的帽子是戴在美國身上的。
美國消耗資源是天經地義,而中國一旦發展,就被扣上破壞生態、漠視全球利益的帽子。(“公知女神”柴靜之前被指接受國外機構資助,然後赴美產子後女兒獲美國國籍)
MJ傑克遜曾經説過一句名言:Lies run sprints but the truth runs marathons.(謊言就像是百米短跑,而真相就像是馬拉松)。在2000年的吉尼斯世界紀錄大全裏認證他資助過39個慈善機構,捐款超3億美元,超過其他任何一位藝術家。
MJ傑克遜因為不願意被控制而被美國民主黨政客及控制的主流媒體瘋狂誣陷,中傷和惡意歪曲,甚至動用美國情報局。而奧巴馬們無疑就是美國民主黨政客的主要領導者之一。